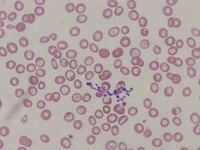
Sideroblastik Anemi Nedenleri?
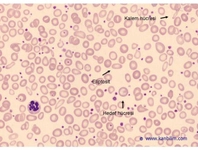
Mikrositik Anemi Nedir?
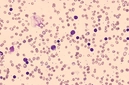
Otoimmün Hemolitik Anemi Belirtileri ve Tedavisi
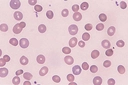
Hemolitik Anemi Belirtileri ve Tedavisi

Kansızlığa İyi Gelen Besinler?
Kansızlık, vücutta yeterli kırmızı kan hücresinin bulunmaması durumudur. Demir eksikliği anemisi en yaygın türüdür. Bu yazıda, kansızlığa iyi gelen besinler ve bu besinlerin sağladığı faydalar ele alınmaktadır. Beslenme alışkanlıkları, kansızlığın önlenmesi ve tedavisinde büyük rol oynamaktadır.
Kansızlığa İyi Gelen Besinler Kansızlık, genel olarak vücutta yeterli miktarda sağlıklı kırmızı kan hücresinin bulunmaması durumudur. Bu durum, anemi olarak da adlandırılmakta ve birçok sağlık problemini beraberinde getirmektedir. Kansızlığın en yaygın türü demir eksikliği anemisidir. Bu nedenle, kansızlığı önlemek veya tedavi etmek için beslenme alışkanlıklarının gözden geçirilmesi büyük önem taşımaktadır. İşte kansızlığa iyi gelen besinler ve bu besinlerin sağladığı faydalar. 1. Kırmızı Et Kırmızı et, yüksek demir içeriği ile bilinir. Özellikle sığır eti, demir açısından zengin bir kaynaktır. Demirin hemoglobinde bulunması, kırmızı kan hücrelerinin üretiminde kritik bir rol oynar.
2. Tavuk ve Hindi Tavuk ve hindi, demir açısından zengin olan diğer bir alternatif kaynaktır. Özellikle tavuk ciğeri, demir içeriği açısından oldukça zengindir.
3. Balık Balık, omega-3 yağ asitleri ve demir açısından zengin bir besindir. Özellikle sardalya ve ton balığı gibi yağlı balıklar, besin değeri yüksek seçeneklerdir.
4. Yeşil Yapraklı Sebzeler Ispanak, pazı ve kara lahana gibi yeşil yapraklı sebzeler, demir ve folat açısından zengin besinlerdir. Bu sebzeler, bitkisel kaynaklı demir içerir.
5. Kuruyemişler ve Tohumlar Badem, fındık, ceviz ve kabak çekirdeği gibi kuruyemişler ile chia ve keten tohumu, demir ve sağlıklı yağlar açısından zengindir.
6. Baklagiller Nohut, mercimek ve fasulye gibi baklagiller, demir, protein ve lif açısından zengin olup, vejetaryenler için mükemmel bir besin kaynağıdır.
7. Tam Tahıllar Tam buğday, yulaf ve kahverengi pirinç gibi tam tahıllar, demir ve B vitaminleri açısından zengin besinlerdir.
Sonuç Kansızlık, vücutta birçok olumsuz etkiye yol açan bir durumdur. Yukarıda belirtilen besinler, demir eksikliğini gidermeye yardımcı olabilir. Bunun yanı sıra, C vitamini açısından zengin meyve ve sebzeler (örneğin portakal, çilek ve brokoli) ile birlikte tüketildiğinde demirin emilimini artırır. Sağlıklı bir diyet, kansızlığın önlenmesi ve tedavi edilmesi açısından büyük önem taşımaktadır. Beslenme alışkanlıklarınızı gözden geçirerek, bu besinleri diyetinize eklemeyi düşünebilirsiniz. Ekstra Bilgiler Kansızlık tedavisinde, yalnızca beslenme değil, aynı zamanda düzenli sağlık kontrolleri ve doktor önerileri de önemlidir. Eğer kansızlık belirtileri yaşıyorsanız, mutlaka bir sağlık uzmanına başvurmalısınız. |

Kansızlığı önlemek için günlük beslenme rutini nasıl olmalı? Kuzu ciğeri tüketmek gerçekten bu kadar faydalı mı, yoksa dikkat etmem gereken başka şeyler var mı?
İtkan, kansızlığı önlemek için dengeli ve çeşitli bir beslenme rutini benimsemek önemlidir. Kuzu ciğeri, demir ve B12 vitamini bakımından zengin olduğu için kansızlığa karşı faydalı olabilir, ancak sadece ciğer yemek yeterli değildir.
Günlük beslenme rutininizde şunlara dikkat edebilirsiniz:
1. Demir Bakımından Zengin Besinler: Kırmızı et, beyaz et, balık, deniz ürünleri, baklagiller, kuru yemişler ve yeşil yapraklı sebzeler.
2. C Vitamini: Demir emilimini arttırmak için portakal, limon, domates, biber gibi C vitamini zengin besinler tüketin.
3. Folik Asit: Yeşil yapraklı sebzeler, narenciye ve tam tahıllar folik asit kaynağıdır.
4. B12 Vitamini: Et, süt ürünleri ve yumurta gibi hayvansal kaynaklardan yeterli B12 almak önemlidir.
Ayrıca, çay ve kahve tüketimini yemekten hemen sonra yapmamaya dikkat etmelisiniz, çünkü bu içecekler demir emilimini azaltabilir. Dengeli ve çeşitli bir beslenme ile kansızlığı önlemek mümkündür.